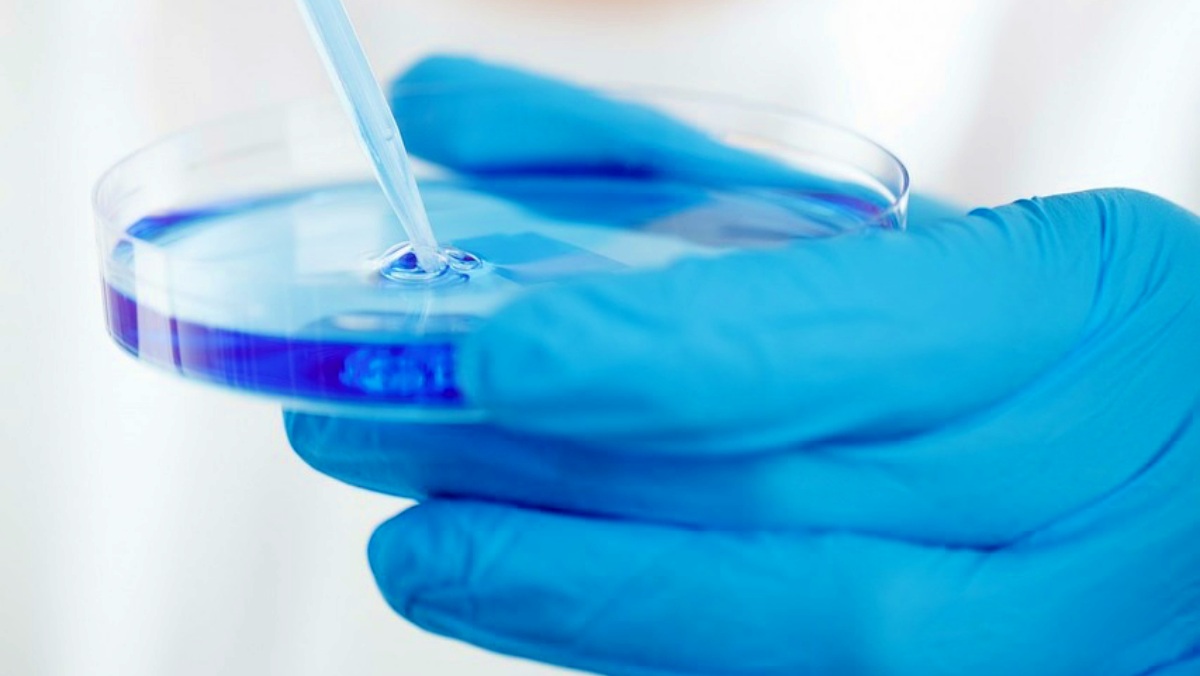

La Consejería de Educación del Gobierno de Castilla-La Mancha publicaba el inicio para la contratación del suministro de importante material para un Ciclo Formativo que se imparte en Albacete. En concreto, la Plataforma de Contratación del Estado recogía la publicación de los pliegos para la adquisición de un procesador de tejidos de carrusel y dos microtomos de rotación manual, imprescindibles para el desarrollo curricular del Ciclo Formativo de Técnico Superior en Anatomía Patológica y Citodiagnóstico.
Contrato de mas de 41.580 euros en Albacete
Este Ciclo Formativo se imparte en el IES Al-Basit de Albacete y según detalla la información publicada en la Plataforma de Contratación del Estado el valor estimado del contrato para el suministro de este equipamiento educativo es de 34.367 euros (IVA excluido). De este modo, si añadimos la correspondiente cuantía al IVA el importe asciende a un total de 41.584 euros.
Se trata de un contrato de suministro dividido en dos lotes según se extrae del Pliego de Prescripciones Técnicas. El Lote 1 consiste en un procesador de tejidos tipo carrusel con capacidad para fijar, deshidratar, aclarar e infiltrar los tejidos y con los accesorios necesarios para su uso en un entorno educativo que remedie las condiciones reales de trabajo en el laboratorio de Anatomía Patológica.
El Lote 2 consistirá en dos microtomos manuales de rotación con los accesorios necesarios para su uso en entorno educativo. Además, cabe destacar que los equipamientos contemplados en ambo lotes deberán ofrecer una capacitación profesional acorde con la realidad sanitaria a estos estudiantes en Albacete.
Requisitos de este contrato de material educativo en Albacete
Se detalla en este mismo documento que los costes del trasporte de las máquinas hasta el lugar de su instalación dentro del aula indicada correrá a cargo de la empresa adjudicataria. Además, la adjudicataria se comprometerá a la instalación del equipo con todos sus componentes en un plazo de 5 semanas, así como proceder a la puesta en marcha de los mismos.
La empresa adjudicataria de cada uno de los lotes de este contrato deberá garantizar cada máquina un mínimo de 2 años desde su puesta en marcha.